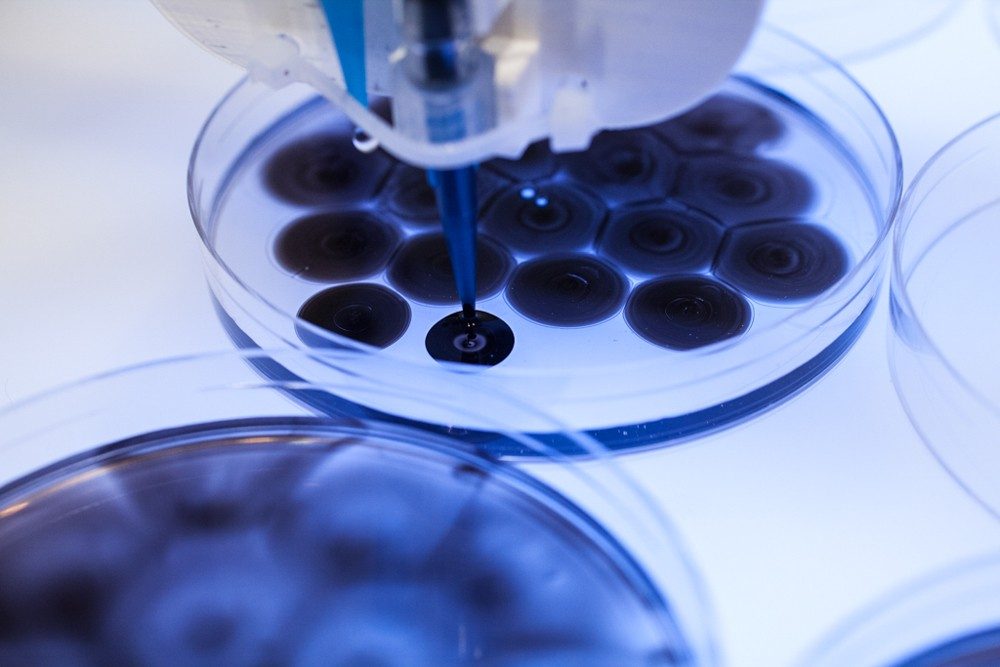
Oron Catts Ionat Zurr_Mechanism of Life.jpg

艺术与科技交融下的生态思考与未来演化探索
首届北京艺术与科技双年展 (BATB) “合成生态” (Synthetic Ecology) 将于2022年9月22日至12月31日在798CUBE举行。中央美术学院携手798,基于「未·未来」(Future Unknown) 全球倡议进行战略合作,以此为起点,共同发起北京艺术与科技双年展。双年展以“合成生态” (Synthetic Ecology) 为题,邀请来自全球50位著名艺术家、科学家、生态学家,以不同的方式回应我们这个危机与生机并存时代的突出症候。其中,25件艺术作品在中国首次亮相,15件艺术作品于2021-2022年期间最新创作。此外,重磅亮相于2021年英国格拉斯哥第26届联合国气候大会 (COP26) 的“气候时钟” (Climate Clock) 项目将在双年展中呈现,这也是这个最具现实性与反思性的项目首次亮相中国。
20世纪70年代,英国科学家詹姆斯·洛夫洛克 (James Lovelock) 首次提出“盖娅假说” (Gaia hypothesis),将地球看作一个超级有机体。这种全新的审视生命的方式,认为地球是“活”的,能够自我调节,维系生命体系的稳定性和持续性。
地球是一个生态系统,我们被裹挟在由自然、社会、精神等所相互交织的“多重生态” (multiple ecologies) 之中。北京艺术与科技双年展 (BATB) 以“合成生态” (Synthetic Ecology) 为题,旨在探讨“共生本体” (symbiontics),同时借由“合成” (synthetic) 这一隐喻,探寻重塑自然的可能性,检视后人类的生态想象,进而形塑一种新的本体论层面的平等观。本次主题质疑人类在生态体系中的主宰地位,正视万物的能动性的同时,重新审视生态体系中彼此复杂而紧密的牵连。“合成生态”由“激变的自然”(Radical Nature)、“缠绕的生命” (Entangled Life)、“交织的演化” (Interwoven Evolution) 三个部分构成,将思索的视界从人/社会推至万物/宇宙,在行星视角与行星尺度 (planetary scale) 中探讨未来演化的可能性。
“ 激变的自然 ”
Radical Nature
今天,新兴科技的涌现营造出了一种全新的生态观“超自然”(hyper-nature)。自然与人工的分野被科学技术的进步所弥合,我们正在创造的世界,既非由自然伟力亦非由科学逻辑所操控,而是由二者缠绕的力量所支配。内里·奥克斯曼 (Neri Oxman) 借助生物技术、材料科学和数字制造技术设计“超自然”生态,在此之中,“生长”与“制造”缠绕互渗。亚历山德拉·黛西·金斯堡 (Alexandra Daisy Ginsberg) 以数字化的形式复活已经消亡的物种,使之在非自然的环境下获得生命。科学技术的力量赋予“存在”以全新的意义,并正在召唤着另一种现实的来临。
 《图腾》,内里·奥克斯曼与介导物质组,2019年,效果图由Luxigon工作室的艾瑞克·布罗什·库姆斯制作,图片由内里·奥克斯曼与介导物质组提供Totems, Neri Oxman and The Mediated Matter Group, 2019. Render by Eric de Broche des Combes, Luxigon. Image courtesy of Neri Oxman and The Mediated Matter Group.
《图腾》,内里·奥克斯曼与介导物质组,2019年,效果图由Luxigon工作室的艾瑞克·布罗什·库姆斯制作,图片由内里·奥克斯曼与介导物质组提供Totems, Neri Oxman and The Mediated Matter Group, 2019. Render by Eric de Broche des Combes, Luxigon. Image courtesy of Neri Oxman and The Mediated Matter Group.
 《晚祷》,内里·奥克斯曼与介导物质组,2018年,图片:约拉姆·雷谢夫,由内里·奥克斯曼与介导物质组提供Vespers, Neri Oxman and The Mediated Matter Group, 2018. Image: Yoram Reshef, courtesy of Neri Oxman and The Mediated Matter Group.
《晚祷》,内里·奥克斯曼与介导物质组,2018年,图片:约拉姆·雷谢夫,由内里·奥克斯曼与介导物质组提供Vespers, Neri Oxman and The Mediated Matter Group, 2018. Image: Yoram Reshef, courtesy of Neri Oxman and The Mediated Matter Group.
 《火星野生化》,亚历山德拉·黛西·金斯堡,2019年,图片 © 亚历山德拉·黛西·金斯堡The Wilding of Mars, Alexandra Daisy Ginsburg, 2019. Image © Alexandra Daisy Ginsberg.
《火星野生化》,亚历山德拉·黛西·金斯堡,2019年,图片 © 亚历山德拉·黛西·金斯堡The Wilding of Mars, Alexandra Daisy Ginsburg, 2019. Image © Alexandra Daisy Ginsberg.
 《替代》,亚历山德拉·黛西·金斯堡,2019年,图片 © 亚历山德拉·黛西·金斯堡The Substitute, Alexandra Daisy Ginsberg, 2019. Image © Alexandra Daisy Ginsberg.
《替代》,亚历山德拉·黛西·金斯堡,2019年,图片 © 亚历山德拉·黛西·金斯堡The Substitute, Alexandra Daisy Ginsberg, 2019. Image © Alexandra Daisy Ginsberg.
 《虚空画(置于培养皿中)》,苏珊妮·安克尔,2016年,图片由艺术家提供Vanitas (in a Petri dish), Suzanne Anker, 2016. Image courtesy of the artist.
《虚空画(置于培养皿中)》,苏珊妮·安克尔,2016年,图片由艺术家提供Vanitas (in a Petri dish), Suzanne Anker, 2016. Image courtesy of the artist.
“缠绕的生命”
Entangled Life
罗西·布拉伊多蒂 (Rosi Braidotti) 将当下世界的后人类境况描述为一种自然-文化的连续统一性,派翠西亚·匹斯尼尼 (Patricia Piccinini) 的作品强调了不同的生命形态之间的异质交错,这种对“混杂性”的致敬,揭示了我们与万物“共生起源” (symbiogenesis)、忧患与共。奥隆·卡茨 (Oron Catts) 和爱奥纳特·祖尔 (Ionat Zurr) 从文化层面探究生命机制,通过创造“原细胞”重现勒杜克的实验来重新思索生命的未来图景。特瑞可·哈波亚 (Terike Haapoja) 对生命的凝视,则在生与死的瞬息之间,呼吁一种对生命哲思的重申。

《亲属》,派翠西亚·匹斯尼尼,2018年,图片由艺术家提供Kindred, Patricia Piccinini, 2018. Image courtesy of the artist.
 《花》,派翠西亚·匹斯尼尼,2015年,图片由艺术家提供Bootflower, Patricia Piccinini, 2015. Image courtesy of the artist.
《花》,派翠西亚·匹斯尼尼,2015年,图片由艺术家提供Bootflower, Patricia Piccinini, 2015. Image courtesy of the artist.
 《Surrogate》,派翠西亚·匹斯尼尼,2005年,图片由艺术家提供Surrogate, Patricia Piccinini, 2005. Image courtesy of the artist.
《Surrogate》,派翠西亚·匹斯尼尼,2005年,图片由艺术家提供Surrogate, Patricia Piccinini, 2005. Image courtesy of the artist.
《生命机制》,奥隆·卡茨、爱奥纳特·祖尔,2011年,图片 © 组织培养和艺术项目(奥隆·卡茨、爱奥纳特·祖尔)The Mechanism of Life, Oron Catts and Ionat Zurr, 2011. Image © The Tissue Culture & Art Project (Oron Catts and Ionat Zurr)
《生命机制》,奥隆·卡茨、爱奥纳特·祖尔,2011年,图片 © 组织培养和艺术项目(奥隆·卡茨、爱奥纳特·祖尔)The Mechanism of Life, Oron Catts and Ionat Zurr, 2011. Image © The Tissue Culture & Art Project (Oron Catts and Ionat Zurr)
 《群体》,特瑞可·哈波亚,2009年,图片 © 特瑞可·哈波亚Community, Terike Haapoja, 2009. Image © Terike Haapoja.
《群体》,特瑞可·哈波亚,2009年,图片 © 特瑞可·哈波亚Community, Terike Haapoja, 2009. Image © Terike Haapoja.
“ 交织的演化 ”
Interwoven Evolution
从一粒星辰到充满生命的星球,在生命进化进程的任何一个阶段“人”与“非人”之间并未有过断裂。生存总是和他者相关,我们需要重思自身与一株植物、一粒尘埃、一涓细流或一隅星辰之间的依存关系,进而检视生态系统自身不断递变流转的特质。倾听万物,敬畏万物,不论是梁绍基先生与蚕相伴30年,还是里米尼记录 (Rimini Protokoll) 水母启示的末日预言,亦或斯佩拉·彼得里奇 (Špela Petrič) 倾听植物的“沉默之语”,种种超越人类的相遇 (other-than-human encounters) 不仅回应了凯伦·巴拉德 (Karen Barad) “彼此缠绕的存在” (entangled existence) 这一概念,也催生出一种行星意识 (planetary consciousness) 来思索未来演化的可能性。
 《双赢》,里米尼记录,2017年,图片 © 大卫·帕里 / 伦敦皇家艺术学院win > < win, Rimin Protokoll, 2017. Image © David Parry/Royal Academy of Arts, London
《双赢》,里米尼记录,2017年,图片 © 大卫·帕里 / 伦敦皇家艺术学院win > < win, Rimin Protokoll, 2017. Image © David Parry/Royal Academy of Arts, London
 《皮肤》,梁绍基,2019-2021年,拍摄:梁绍基Skin, Liang Shaoji, 2019-2021. Photo by the artist.
《皮肤》,梁绍基,2019-2021年,拍摄:梁绍基Skin, Liang Shaoji, 2019-2021. Photo by the artist.
 《降临》,向京,2019年,图片 © 向京工作室Descending, Xiang Jing, 2019. Image © Xiang Jing Studio.
《降临》,向京,2019年,图片 © 向京工作室Descending, Xiang Jing, 2019. Image © Xiang Jing Studio.
 《隐形之言》,斯佩拉·彼得里奇,2018,图片 © 米哈·弗拉斯Institute of Inconspicuous Languages: Reading Lips, Špela Petrič, 2018. Image © Miha Fras.
《隐形之言》,斯佩拉·彼得里奇,2018,图片 © 米哈·弗拉斯Institute of Inconspicuous Languages: Reading Lips, Špela Petrič, 2018. Image © Miha Fras.
 《网络的自然历史》,拉尔夫·贝克尔,2021年,图片 © 拉尔夫·贝克尔 A Natural History of Networks / SoftMachine, Ralf Baecker, 2021. Images © Ralf Baecker.
《网络的自然历史》,拉尔夫·贝克尔,2021年,图片 © 拉尔夫·贝克尔 A Natural History of Networks / SoftMachine, Ralf Baecker, 2021. Images © Ralf Baecker.
北京艺术与科技双年展 (BATB) 试图在全球范围内构建一个艺术与科技对话的平台,透过数字技术等新兴媒介,共同探讨人类、科技与未来的深刻议题。此外,本届北京艺术与科技双年展 (BATB) 发起了特别项目“气候关怀” (Climate Care),这是国内首个聚焦探索“气候危机”与“艺术+科技”交叉领域的倡议。
“气候关怀”以“Care”作为行动,通过“艺术+科技”推动全球气候合作,共同应对气候变化带来的挑战。“气候关怀”汇集了来自全球艺术、科技、生态以及决策领域的参与者,共同审视当下迫切的气候危机,探讨“艺术+科技”如何有效地参与并促进气候行动。“气候关怀”倡议自发布以来,持续推进气候行动创新,先后发起了“气候时钟” #ActInTimeChina (刻不容缓)、“气候宣言” (Climate Declaration) 等持续引领行动的项目,并将于2022年11月6日至18日第27届联合国气候大会 (COP27) 期间举办“气候谈判” (Climate Negotiation)。此外,“气候关怀”将借助Web3和区块链技术构建“Climate DAO”为气候行动开辟全新的路径。
北京艺术与科技双年展 (BATB) 将持续至2022年12月31日,双年展期间还将呈现系列学术分享,邀请全球著名学者围绕“生态”、“气候”、“行星缠绕” (planetary entanglement)、“共生本体” (symbiontics) 等议题进行回应,其中包括MIT教授卡洛琳·A·琼斯 (Caroline A. Jones)、艺术家安妮卡·易 (Anicka Yi)、策展人斯蒂芬妮·赫斯勒 (Stefanie Hessler) 、艺术史学家、文化评论家、创意生态中心 (Center for Creative Ecology) 创始人T.J.迪莫斯 (T.J.Demos)、维也纳应用艺术/现代艺术博物馆 (MAK) 的馆长、维也纳变革双年展总监克里斯托夫·滕-霍亨斯坦 (Christoph Thun-Hohenstein)、GIGA全球性倡议发起人克里斯托弗·法比安 (Christopher Fabian) 等,敬请期待!
展览信息
北京艺术与科技双年展 (BATB) “合成生态”
Beijing Art and Technology Biennale (BATB)
“Synthetic Ecology”
2022年9月22日至12月31日
798CUBE
参展艺术家 Participating Artists
亚历山德拉·黛西·金斯堡 Alexandra Daisy Ginsberg
安娜·杜米特里乌&亚历克斯·梅 Anna Dumitriu & Alex May
向京 Xiang Jing
内里·奥克斯曼与介导物质小组 Neri Oxman and The Mediated Matter Group
奥隆·卡茨&爱奥纳特·祖尔 Oron Catts & Ionat Zurr
派翠西亚·匹斯尼尼 Patricia Piccinini
拉尔夫·贝克尔 Ralf Baecker
罗莎·史密特&莱提斯·史密茨 Rasa Smite & Raitis Smits
里米尼记录 Rimini Protokoll
梁绍基 Liang Shaoji
苏菲·法尔凯斯 Sophie Falkeis
斯佩拉·彼得里奇 Špela Petrič
苏珊·舒普普利 Susan Schuppli
苏珊·安卡尔 Suzanne Anker
特瑞可·哈波亚 Terike Haapoja
terra0 (保罗·库灵、保罗·塞德勒、马克斯·汉普郡) terra0 (Paul Kolling, Paul Seidler, Max Hampshire)
乌苏拉·比尔曼 Ursula Biemann
AoBM 实验室 Art of Bio Machine
气候时钟 Climate Clock
(按姓氏拼音排序 in alphabetical order)
总顾问 General Counsel
高洪 Gao Hong
范迪安 Fan Di’an
滕彦斌 Teng Yanbin
学术主持 Academic Chairs
苏新平 Su Xinping
张子康 Zhang Zikang
学术顾问 Academic Advisors
乔瓦尼·阿洛伊 Giovanni Aloi
许煜 Yuk Hui
姜宇辉 Jiang Yuhui
张尕 ZHANG Ga
(按姓氏拼音排序 in alphabetical order)
总策划 Director
宋协伟 Song Xiewei
展览总监 Exhibition Director
李东妊 Hera Lee
策展人 Curators
陈小文 Chen Xiaowen
王乃一 Wang Naiyi
行政统筹 Administrative Coordinator
董焕琴 Dong Huanqin
车静 Che Jing
温猛 Wen Meng
展览统筹 Assistant Curators
孙宇航 Sun Yuhang
王碧云 Rachel Be-Yun Wang
展览执行 Exhibition Execution
秦政 Qin Zheng
媒体统筹 Media Coordinator
石雨萌 Shi Yumeng
刘金龙 Liu Jinlong
运营统筹 Operation Coordinator
崔美花 Cui Meihua
庞欣妍 Pang Xinyan
郭逊博 Guo Xunbo
设备统筹 Technical Coordinator
王东翰 Wang Donghan
视觉设计 Visual Design
4aC Design
展览设计 Exhibition Design
马鑫 Ma Xin
孙楚杨 Sun Chuyang
主办 Host
中央美术学院 Central Academy of Fine Arts
北京七九八文化科技有限公司
Beijing 798 Culture Technology Co., Ltd.
承办 Organizer
中央美术学院设计学院 d-School, Central Academy of Fine Arts
798CUBE
网龙网络公司 NetDragon Websoft Inc.
协办 Co-organizer
奥地利驻华大使馆文化处 Kulturforum der Österreichischen Botschaft Peking
气候行动伙伴 Climate Action Partner
世界自然基金会 World Wide Fund for Nature
生态共建伙伴 Ecological Collaborator
ORGANY
声音独家支持 Exclusive audio support
北京光合积木文化传播有限责任公司 Beijing Guanghe Jimu LLC.
《双赢》作品独家支持
Exclusive artwork support for win > < win
北京月光水母科技有限公司
Beijing Moonjelly Technology Co., Ltd.




